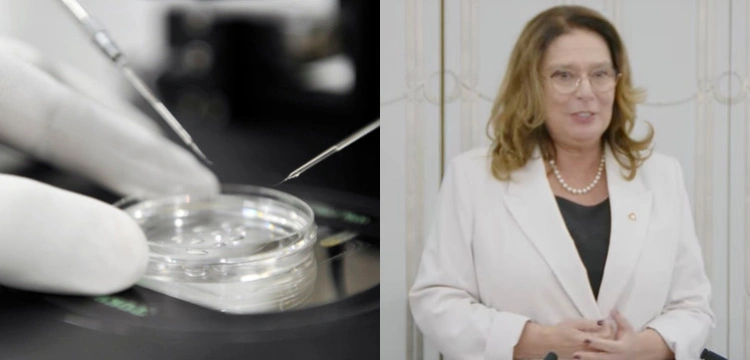
Senat poparł ustawę ws. in vitro. Teraz decyzja należy do prezydenta

Ustawa przewiduje, że na program leczenia niepłodności obejmujący zapłodnienie pozaustrojowe każdego roku państwo będzie musiało przeznaczyć przynajmniej 500 mln zł.
- „To bardzo dobry początek naszych prac”
- mówiła po głosowaniu marszałek Małgorzata Kidawa-Błońska.
- „Nie wyobrażam sobie, żeby prezydent Andrzej Duda nie podpisał ustawy o finansowaniu in vitro z budżetu państwa, tak potrzebnej dla tysięcy Polaków; ta ustawa da szczęście ludziom”
- dodała.
Wcześniej szef gabinetu prezydenta Marcin Mastalerek zapowiedział, że wedle jego wiedzy Andrzej Duda „nie będzie blokował projektu ustawy o refundacji in vitro”. Tymczasem pod adresem stawiamnazycie.pl zbierane są podpisy pod apelem do prezydenta o zawetowanie ustawy.
- „Panie Prezydencie, wszyscy wiemy, że tzw. metoda in vitro nie tylko nie leczy niepłodności, ale zamiast tego przynosi krwawe eugeniczne żniwo wobec wszystkich tych istot ludzkich, które nie zostaną wyselekcjonowane do dalszego rozwoju i narodzin”
- napisano w apelu.